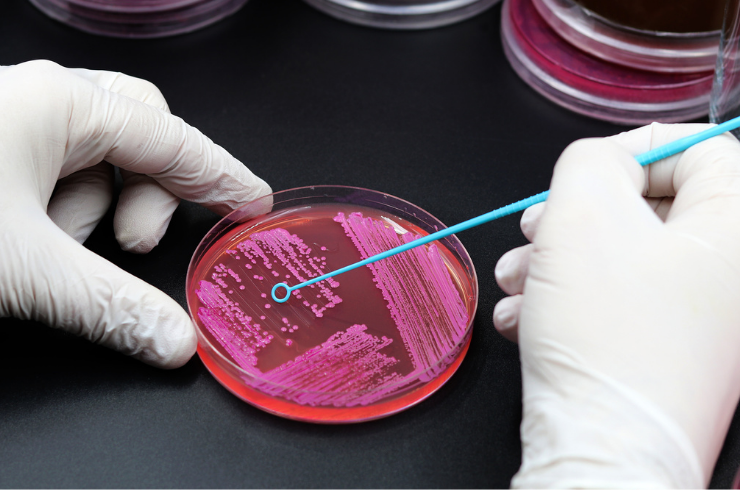

Microbiology Tests
Microbiology tests help detect and identify harmful microorganisms like bacteria, viruses, fungi, and parasites that can cause infections and diseases.
Why Microbiology Tests are Important
- Accurate Infection Detection: Identifies the specific microorganism causing illness for targeted treatment.
- Guiding Effective Treatment: Determines the most suitable medication or antibiotic for faster recovery.
- Preventing Disease Spread: Helps control contagious infections by confirming diagnosis and initiating timely care.
- Monitoring Treatment Response: Tracks progress to ensure the infection is fully resolved.
Common Microbiology Tests We Offer
- Urine Culture and Sensitivity: Detects bacteria in urine and identifies effective antibiotics for treatment.
- Blood Culture: Finds bacteria or fungi in the blood to diagnose severe infections.
- Stool Culture: Identifies pathogens in stool samples to detect digestive system infections.
- Sputum Culture: Checks for lung infections like pneumonia or tuberculosis.
- Wound Swab Culture: Detects bacteria from wounds to guide proper antibiotic therapy.
At Diagnocare Medi Lab, our microbiology testing services use advanced methods to deliver fast, precise results for better infection management.
Our Services